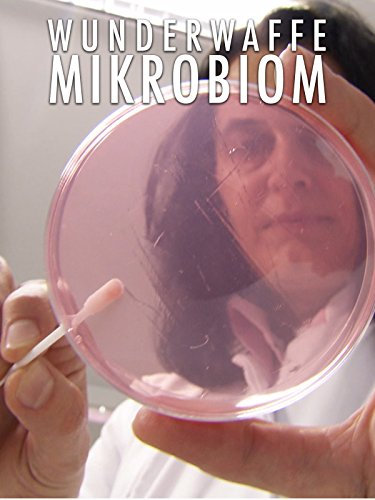
Wunderwaffe Mikrobiom

Gabel statt Skalpell: Das Vegan-Kochbuch

Auf Amazon anzeigen
Auf Amazon anzeigen
Preisvergleich

2,89 €
11,99 €
Zum Shop

19,99 €
Versand frei | 1-2 Tage
Zum Shop

1,99 €
Zum Shop

19,99 €
3,95 € | 1-2 Tage
Zum Shop

19,99 €
3,00 € | 2-3 Tage
Zum Shop

19,99 €
3,95 €
Zum Shop

19,99 €
Versand frei
Zum Shop
Preisentwicklung
Diese Gabeln Statt Skalpell könnten Sie auch interessieren.

Der kluge Bauch - unser zweites Gehirn
Preis prüfen

Heilen ohne Pillen und Skalpell
Versand frei
Preis prüfen
Wunderwaffe Mikrobiom
Versand frei
Preis prüfen

Unser Essen - Was uns fit hält
Versand frei
Preis prüfen
![Bowling for Columbine [dt./OV]](https://cdn.which.one/productimages/E/H/A/B00ESURAHE.jpg)
Bowling for Columbine [dt./OV]
Versand frei
Preis prüfen

Preis prüfen

Versand frei
Preis prüfen

Gabel statt Skalpell: Das Vegan-Kochbuch
Scorpio Verlag
Versand frei
Preis prüfen

Gabel statt Skalpell: Gesund durch Ernährung auf pflanzlicher Grundlage
Scorpio Verlag
Versand frei
Preis prüfen

Forks Over Knives - The Cookbook
Book - forks over knives over 300 recipes for plant-based eating all though the year
Preis prüfen

The Forks Over Knives Plan: How to Transition to the Life-Saving, Whole-Food, Plant-Based Diet
Simon & Schuster
Preis prüfen

Forks Over Knives Family: Every Parent's Guide to Raising Healthy, Happy Kids on a Whole-Food, Plant-Based Diet
Simon & Schuster
Versand frei
Preis prüfen

Narayana Verlag GmbH Vegane Indische Küche: Traditionelle und kreative Rezepte zum Nachkochen
Unimedica
Versand frei
Preis prüfen

Das offizielle Kochbuch zur China Study: Über 120 vegane Rezepte
RIVA
Versand frei
Preis prüfen

Be Useful: Sieben einfache Regeln für ein besseres Leben
Farbe White
Versand frei
Preis prüfen

Stuhl-Yoga für Senioren über 60: 28-Tage-Herausforderung | Anfänger, Mittelstufe und Fortgeschrittene | Verbessern Sie Ihre Mobilität, Herzgesundheit und nehmen Sie in 10 Minuten pro Tag ab!
Independently published
Versand frei
Preis prüfen

Skalpell, Tupfer, Liebe
Ylva Verlag e.Kfr.
Versand frei
Preis prüfen

Forks Over Knives Cookbook
Aurosory ltd
Versand frei
Preis prüfen

An Unconditional Faith: Forks in the Road Revisited! (English Edition)
Versand frei
Preis prüfen

Physician-Soldiers at the Forks: The Impact of the Military on Medical Care in Pittsburgh (1754 - 1900)
Arcadia Publishing
Versand frei
Preis prüfen
© 2025 WHICH.ONE. ALLE INHALTE UNTERLIEGEN UNSEREM COPYRIGHT.